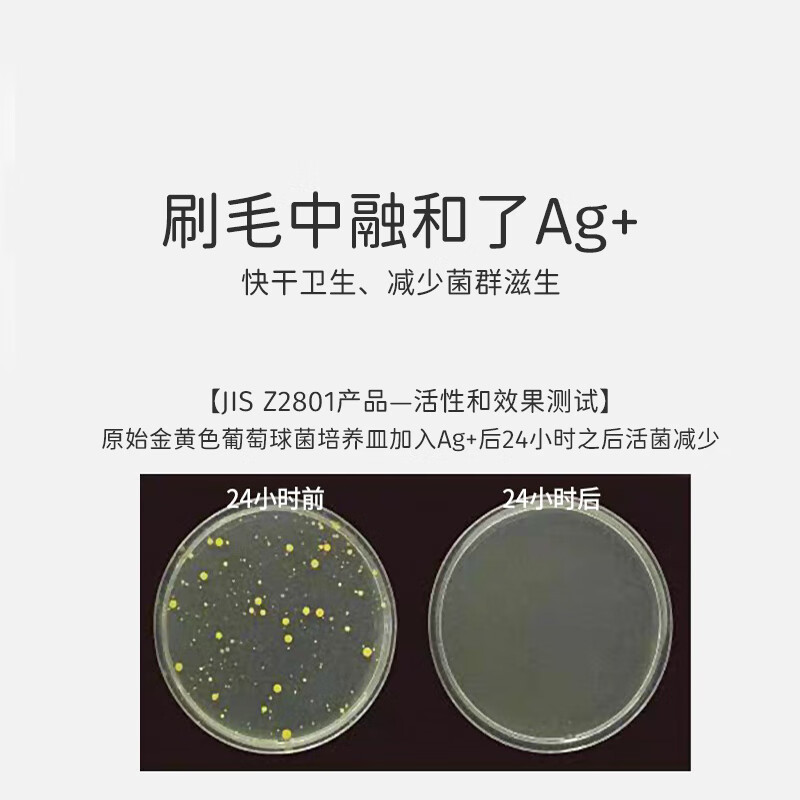
Ci Medical imported silver ion Ag+ quick-drying toothbrush small head medium soft bristles deep cleaning between teeth manual dental 1 pack

Ci Medical imported silver ion Ag+ quick-drying toothbrush small head medium soft bristles deep cleaning between teeth manual dental 1 pack
192.00تومان
- Stock: In Stock
- Model: j100107439843
- Weight: 0.01kg
- Dimensions: 210.00cm x 35.00cm x 20.00cm
- Location: Japan
Create unlimited custom product blocks and display them in accordions or tabs or open blocks. Each block can be assigned to all products at once or specific products according to advanced criteria.
Create unlimited custom product blocks and display them in accordions or tabs or open blocks. Each block can be assigned to all products at once or specific products according to advanced criteria.















